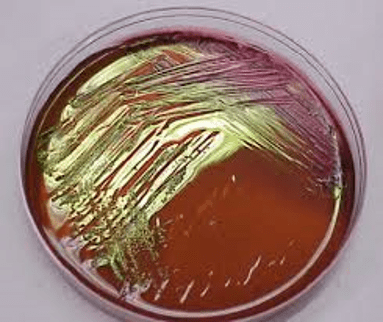

محیط کشت SOYBEAN CASEUN LECTHIN POLYSORBAT 80 کیولب
0
0
SOYBEAN CASEUN LECTHIN POLYSORBAT 80
محیط کشت کیولب